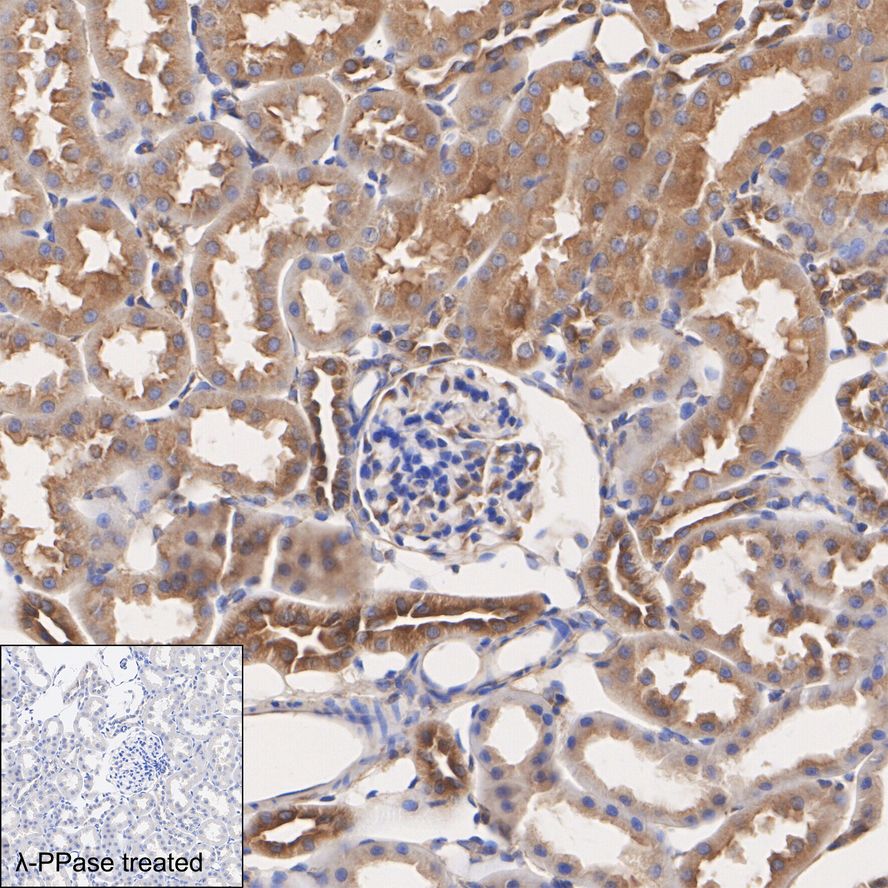

Phospho-PKA R2 (S99) Rabbit Monoclonal Antibody(ARA722)
|
Application |
Dilution Ratio |
|
WB |
1:1,800 - 1:2,000 |
|
IF |
1:50 - 1:200 |
|
IHC |
1:800 - 1:1,000 |
|
IP |
1-2μg/sample |
|
FC |
1:800 - 1:1,000 |
|
Antibody Type |
Recombinant Rabbit monoclonal Antibody |
|
Immunogen |
Synthetic phospho-peptide corresponding to residues surrounding Ser99 of Human PKA R2 aa 82-126 / 404. |
|
Species Reactivity |
Human, Mouse, Rat |
|
Validated Applications |
WB, IF, IHC, IP, FC |
|
Molecular Weight |
Predicted band size: 46 kDa |
|
Positive Control |
PC-12 treated with 100nM Calyculin A for 30 minutes cell lysate, human kidney tissue, mouse kidney tissue, rat kidney tissue, human colon cancer tissue, PC-12 cells treated with 100nM Calyculin A for 30 minutes, PC-12. |
|
Conjugation |
unconjugated |
|
Form |
Liquid |
|
Storage Buffer |
1×TBS (pH7.4), 0.05% BSA, 40% Glycerol. Preservative: 0.05% Sodium Azide. |
|
Isotype |
IgG |
|
Purification Method |
Protein A affinity purified. |

Western blot analysis of Phospho-PKA R2 (S99) on different lysates with Phospho-PKA R2 (S99) Rabbit Monoclonal Antibody(ARA722).

Immunohistochemical analysis of paraffin-embedded rat kidney tissue untreated / treated with λpp with Phospho-PKA R2 (S99) Rabbit Monoclonal Antibody(ARA722).

Immunocytochemistry analysis of PC-12 cells untreated / treated with 100nM Calyculin A for 30 minutes labeling Phospho-PKA R2 (S99) with Phospho-PKA R2 (S99) Rabbit Monoclonal Antibody(ARA722).

Flow cytometric analysis of PC-12 cells labeling Phospho-PKA R2 (S99). Phospho-PKA R2 (S99) Rabbit Monoclonal Antibody(ARA722).

Phospho-PKA R2 (S99) was immunoprecipitated from 0.2 mg PC-12 cell lysate with Phospho-PKA R2 (S99) Rabbit Monoclonal Antibody(ARA722).
 New Products
New Products